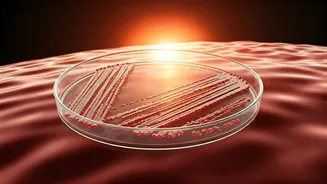
Mumbai's Heatwave Fuels 50% Rise in Gut Infections: A Case Study and Prevention Guide

What is the story about?
The Directorate of Revenue Intelligence (DRI) busted a gold smuggling racket at Chhatrapati Shivaji Maharaj International Airport (CSMIA) in Mumbai and arrested 24 female carriers with 29.37 kilograms of gold worth ₹37.74 crore, an official said on Thursday.
Based on specific intelligence, the DRI Mumbai Zonal Unit conducted ‘Operation Dhahabu Blitz’ on Wednesday, he said, adding it may be among the biggest busts at Mumbai airport this year. ‘Dhahabu’ is Swahili for gold.
“DRI received a tip-off about women coming from Nairobi in Kenya with hidden gold. Following this, 24 foreign nationals, who had landed at Mumbai Airport from Nairobi, were stopped. From their bags and clothes, 25.10 kg of gold bars and 4.27 kg of gold jewellery were recovered,” he said.
Also Read | Fire breaks out at Mumbai airport’s Terminal 1
The women were trained to hide the gold and escape checks, and it shows a well-planned syndicate using such carriers to beat airport security, the official pointed out.
While the women will be produced in court, further probe is underway to nab the kingpins of the racket, the official said.
Based on specific intelligence, the DRI Mumbai Zonal Unit conducted ‘Operation Dhahabu Blitz’ on Wednesday, he said, adding it may be among the biggest busts at Mumbai airport this year. ‘Dhahabu’ is Swahili for gold.
“DRI received a tip-off about women coming from Nairobi in Kenya with hidden gold. Following this, 24 foreign nationals, who had landed at Mumbai Airport from Nairobi, were stopped. From their bags and clothes, 25.10 kg of gold bars and 4.27 kg of gold jewellery were recovered,” he said.
Also Read | Fire breaks out at Mumbai airport’s Terminal 1
The women were trained to hide the gold and escape checks, and it shows a well-planned syndicate using such carriers to beat airport security, the official pointed out.
While the women will be produced in court, further probe is underway to nab the kingpins of the racket, the official said.